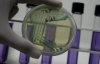
Кишкова інфекція почала вбивати французів

Німецький державний інститут контролю за захворюваннями оголосив про те, що епідемія кишкової палички E.coli в Європі закінчилася. Протягом останніх трьох тижнів не було зафіксовано жодного нового випадку хвороби, повідомляє Reuters.
"Найбільший спалах E.coli в Німеччині закінчився", - заявив Райнхард Бургер, голова інституту Роберта Коха, державного агентства з контролю за захворюваннями.
Хворобу перенесли майже 4,5 тисячі жителів Європи і Північної Америки. Велике вогнище захворювання був у Північній Німеччині. Крім того, велика кількість захворювань була зафіксована в французькому місті Бордо.
Джерелом епідемії спочатку вважалися огірки, вирощені в Німеччині, проте пізніше з'ясувалося, що найбільш вірогідне джерело бактерії - деякі види насіння, завезені з Єгипту.
Євросоюз дав розпорядження вилучити з продажу все єгипетське насіння, що було завезене з 2009 по 2011 роки. У результаті епідемії Україна заборонила імпорт свіжих фруктів і овочів з Євросоюзу, а європейці стали споживати менше сирих овочів.
Нагадаємо, через бактерію загинуло 50 осіб.

Коментарі